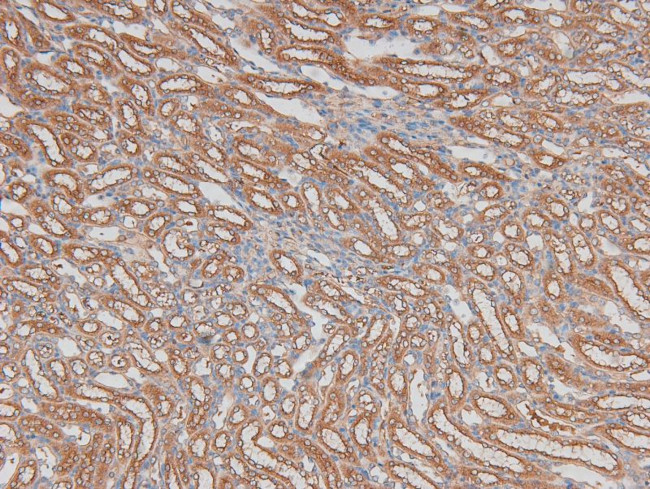
Phospho-ILK (Ser343) Antibody in Immunohistochemistry (Paraffin) (IHC (P))

Search
Invitrogen
Phospho-ILK (Ser343) Polyclonal Antibody
{{$productOrderCtrl.translations['antibody.pdp.commerceCard.promotion.promotions']}}
{{$productOrderCtrl.translations['antibody.pdp.commerceCard.promotion.viewpromo']}}
{{$productOrderCtrl.translations['antibody.pdp.commerceCard.promotion.promocode']}}: {{promo.promoCode}} {{promo.promoTitle}} {{promo.promoDescription}}. {{$productOrderCtrl.translations['antibody.pdp.commerceCard.promotion.learnmore']}}
图: 1 / 5
Phospho-ILK (Ser343) Antibody (PA5-118623) in IHC (P)





产品信息
PA5-118623
宿主/亚型
分类
类型
抗原
偶联物
形式
浓度
规格
保存条件
运输条件
RRID
靶标信息
Transduction of extracellular matrix signals through integrins influences intracellular and extracellular functions, and appears to require interaction of integrin cytoplasmic domains with cellular proteins. Integrin-linked kinase (ILK), interacts with the cytoplasmic domain of beta-1 integrin. This gene encodes a serine/threonine protein kinase with 4 ankyrin-like repeats, which associates with the cytoplasmic domain of beta integrins and acts as a proximal receptor kinase regulating integrin-mediated signal transduction. Multiple alternatively spliced transcript variants encoding the same protein have been found for this gene.
仅用于科研。不用于诊断过程。未经明确授权不得转售。